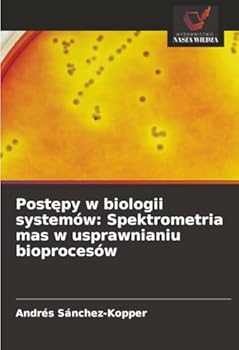
Postepy w biologii systemów: Spektrometria mas w usprawnianiu bioprocesów (Polish Edition)
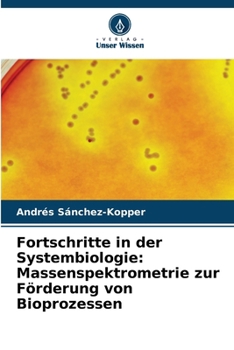
Fortschritte in der Systembiologie: Massenspektrometrie zur Förderung von Bioprozessen (German Edition)

Selected
Refine Your Search
Product Types
Genres
Formats
Conditions
Collectibles
Age Ranges
Languages
Additional Options
Price Range
Exclude

Releases: Apr 14, 2026



If you have order questions or need additional assistance, please visit Help & Support.